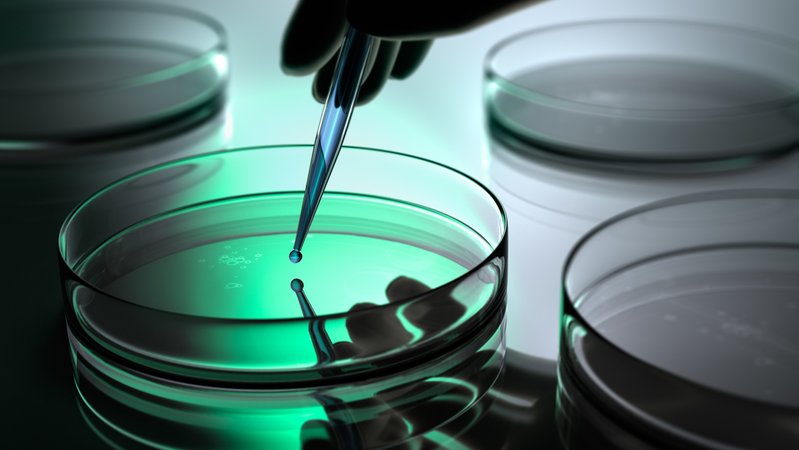
Petrischale in einem Labor. | Bild: stock.adobe.com/peterschreiber.media Petrischale in einem Labor.

Im Stadtgebiet von Pfaffenhofen an der Ilm in Oberbayern sind kürzlich zwei Personen am seltenen Borna-Virus erkrankt. Ein Mann ist jetzt an den Folgen der Infektion verstorben, ein weiterer kämpft in der Intensivstation einer Großklinik in Bayern gegen die Viruserkrankung. Das teilte das Landratsamt Pfaffenhofen am Montag mit.
Wie und wo haben sich die Patienten infiziert?
Den Angaben zufolge sind beide Männer Mitte 50 und nicht miteinander verwandt. Noch ist unklar, ob zwischen den beiden eine Verbindung besteht. Das Bayerische Landesamt für Gesundheit und Lebensmittelsicherheit (LGL) versucht mit Hochdruck herauszufinden, wie die beiden sich infiziert haben.
Bei der Behörde haben sich bereits viele besorgte Bürger gemeldet. Am Donnerstagabend wird unter anderem eine Expertin des LGL die Fragen der Pfaffenhofener Bürger beantworten. Die Veranstaltung findet als Livestream statt und startet um 19 Uhr, wie das Landratsamt Pfaffenhofen an der Ilm am Dienstag mitteilte. Weitere Informationen zu dem Stream und der Veranstaltung gibt es auf der Website des Landratsamts (externer Link). Besorgte Bürger können sich zudem schon jetzt per Mail an servicestelle@lgl.bayern.de wenden.
Borna-Virus wird von Spitzmäusen übertragen
Das Borna Disease Virus 1 (BoDV-1) ist sehr selten und wird in der Regel von Spitzmäusen übertragen. Das LGL empfiehlt deshalb, Spitzmäuse oder ihren Kot nie mit bloßen Händen zu berühren und Orte zu meiden, an denen sie sich aufhalten. Nahrungsquellen wie beispielsweise Katzenfutter oder Küchenmüll sollten unzugänglich gelagert werden, um die Tiere nicht anzulocken.
Tote Tiere in Endemiegebieten sollten ebenfalls nur mit Einmalhandschuhen berührt, anschließend zusätzlich mit handelsüblichem Reinigungsmittel besprüht und in einer geschlossenen Plastiktüte entsorgt werden. Die Institute empfehlen bei der Entsorgung toter Tiere in Endemiegebieten zudem, eine eng anliegende FFP2-Maske zu tragen.
Symptome: Kopfschmerzen, Fieber, Sprachstörungen
Beim Menschen kann die Tierseuche schwere Gehirnentzündungen hervorrufen, eine Infektion verläuft meist tödlich. In den meisten Fällen berichten Betroffene anfangs von einem allgemeinen Krankheitsgefühl, Kopfschmerzen und Fieber. Später kommt es häufig zu neurologischen Einschränkungen wie Sprachproblemen oder motorischen Störungen beim Gehen, bis der Erkrankte nach wenigen Tagen oder Wochen in ein Koma fällt.
Ein Test bei Verdacht auf eine Infektion mit dem Borna-Virus ist nicht möglich, denn einen "Frühtest" gibt es nicht. Eine Infektion kann daher erst im fortgeschrittenen Stadium der Erkrankung festgestellt werden.
Schwerpunkt Bayern – doch auch hier äußerst geringes Risiko
Jährlich erkranken laut dem Robert Koch-Institut (RKI) deutschlandweit bis zu sieben Personen am Borna-Virus. Ein Großteil der Fälle kommt aus Bayern: Todesfälle nach Infektionen gab es in der Vergangenheit beispielsweise in den bayerischen Landkreisen Weißenburg-Gunzenhausen, Mühldorf und Rottal-Inn. Dennoch ist das Infektionsrisiko mit dem Borna-Virus auch in Bayern laut Experten äußerst gering.
Dieser Artikel ist erstmals am 02.06.2025 um 17.32 Uhr auf BR24 erschienen. Am 03.06.2025 um 13.06 Uhr wurde der Artikel um Angaben zur Info-Veranstaltung in Pfaffenhofen an der Ilm ergänzt und aktualisiert.
Im Video: Wie gefährlich ist das Borna-Virus?
Labortest
Im Video: Extrem selten, extrem gefährlich - Das Bornavirus
Eine Gehirnprobe.
Das ist die Europäische Perspektive bei BR24.
"Hier ist Bayern": Der BR24 Newsletter informiert Sie immer montags bis freitags zum Feierabend über das Wichtigste vom Tag auf einen Blick – kompakt und direkt in Ihrem privaten Postfach. Hier geht’s zur Anmeldung!